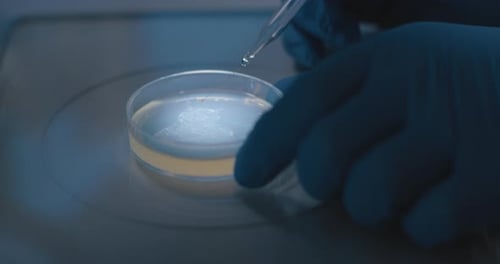
Gloved Hands Use Pipette with Petri Dish in Lab
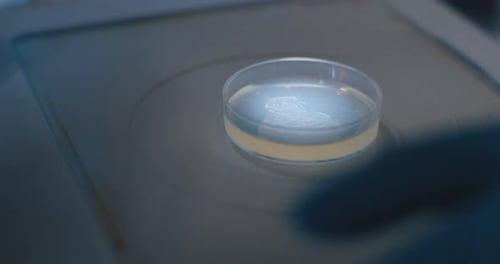
Scientist Drops Liquid into Petri Dish in Lab

Pipette Extracting Liquid for Experiment in Dark Lab
By MonsterFilmmakersOne great value subscription from $16.50/month
- Unlimited downloads of 27+ million creative assets
- AI Tools: video, image and more
- Lifetime commercial license
- Easy cancellation
Already have an account? Sign in
Attributes
- Length
- 0:14
- Resolution
- 4096 x 2160
- File Size
- 606 MB
- Frame Rate
- 25 fps
- Alpha Channel
- No
- Looped
- No
- Video Encoding
- Apple ProRes 422
- Orientation
- Horizontal
- Commercial License
- Further Information
Description
Close up shot of a gloved hand using a pipette to extract liquid from a petri dish, in a lab setting. The scene is dark, with blueish lighting, and would suit themes of experimentation and scientific research. Great for projects related to medical advancements, lab research, or product development.